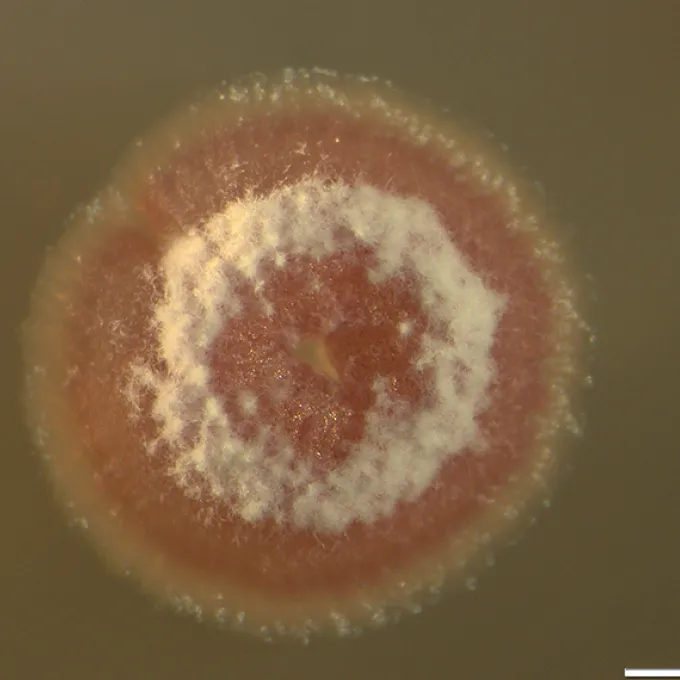

News


White clover’s toxic tricks traced to its hybridization

This Fish Is The Master Of The Poignant Pause

In search of refuge Researchers look at whether Ozark oases at Tyson Research Center — climate change refugia — could help species persist in spite of rising temperatures.

Pakrasi to work on positive farming effort

A brief history of the cabbage butterfly’s evolving tastes

Discovery of CO2-absorbing bacteria in Missouri bolsters wetlands’ importance in combating climate change

What’s Holding Streptomyces Back from Producing Gene-Encoding Drugs?

An ecologist and an engineer come together to create Robotany: a portable, low-cost platform for precise automated aerial imaging of field plots

Depth of perception: In plant cells, a conserved mechanism for perceiving mechanical force resides in unexpected location
When stubborn bugs refuse to make drugs
